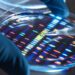
ایجاد اولین نقشه جامع کوادروپلکس DNA با کمک هوش مصنوعی

فهرست مطالب
مأموریت Comet Interceptor با محدودیتهای مهندسی و زمانبندی، به دنبال یافتن دنبالهدار ناشناخته است و احتمالا باید با یک هدف «معمولی» و دادههای محدود کار کند.
به گزارش سرویس علمی تکناک، گمانهزنیهای زیادی پیرامون دنبالهدار بینستارهای 3I/ATLAS مطرح شده که بیشتر ناشی از کیفیت پایین دادههاست، زیرا رصد این جرم تنها از زمین یا در برخی موارد از مریخ ممکن است و فاصله آن از حد ایدهآل بسیار بیشتر است.
با این حال، آینده ممکن است فرصت مشاهده یک جرم بینستارهای جدید را فراهم آورد. آژانس فضایی اروپا (ESA) ماموریتی برنامهریزی کرده است که بتواند یک دنبالهدار ناشناخته جدید یا دنبالهداری که برای اولین بار وارد منظومه شمسی داخلی میشود، رصد کند. با این حال، محدودیتهای ماموریت، نیازمند رعایت مجموعهای از شرایط برای هر هدف بالقوه است. مقالهای جدید، به قلم پروفسور کالین اسنودگرس از دانشگاه ادینبورگ و همکارانش، این شرایط را بررسی کرده و احتمال یافتن یک هدف مناسب در بازه زمانی معقول پس از پرتاب ماموریت را ارزیابی میکند.
ماموریت Comet Interceptor (CI) یک پروژه کلاس F ESA است، به این معنا که توسعه و پرتاب آن سریع خواهد بود. این ماموریت در نقطه لاگرانژ L2 زمین-خورشید مستقر خواهد شد تا زمانی که یک دنبالهدار ناشناخته (Dynamically New Comet یا DNC) شناسایی شود؛ دنبالهداری که برای نخستین بار وارد نواحی داخلی منظومه شمسی میشود. در صورت خوششانسی، این ماموریت میتواند یک جرم بینستارهای عبوری را هم رصد کند، اما احتمال وقوع آن دقیقا در زمانی که CI منتظر است، بسیار کم است.
دنبالهدارهای DNC رایجتر هستند. از سال 1898 تا 2023، 132 مورد ثبت شده است، اما بسیاری از آنها کمنور بوده و تنها چند ماه یا سال قبل از ورود به منظومه شمسی داخلی کشف میشوند. در این میان، پیشبینی میشود ماموریت جدید Legacy Survey of Space and Time (LSST) در رصدخانه Vera C. Rubin تعداد قابل توجهی DNC کشف کند و هشدار کافی برای تیم ماموریت CI فراهم آورد تا اهداف بالقوه را ارزیابی و برای رصد انتخاب کنند.
بیشتر بخوانید: رصد اشعه ایکس دنبالهدار 3I/ATLAS و کشف جزئیات تازه
01
از 02دنبالهدار ناشناخته و دردسرهای رهگیری آن
حتی در صورتی که ماموریت LSST یک دنبالهدار ناشناخته مناسب شناسایی کند، هیچ تضمینی وجود ندارد که دنبالهدار هنگام نزدیک شدن به خورشید به اندازه کافی روشن شود تا برای ماموریت جذاب باشد.
همچنین ممکن است قبل از رسیدن CI به فاصله رصد مناسب، دنبالهدار متلاشی شود. با توجه به اینکه ماموریت تنها یک هدف را میتواند انتخاب کند، این عدم قطعیتها ریسک قابل توجهی ایجاد میکنند. بنابراین بهتر است با استفاده از نظریه بازیها، سناریوهای ممکن را تحلیل کرد تا در زمان انتخاب هدف واقعی، پیشبینی دقیقتری داشته باشیم.
حتما بخوانید: نگاه تازه ناسا و آژانس فضایی اروپا به دنبالهدار میانستارهای 3I/ATLAS + تصویر
CI باید دنبالهدار ناشناخته را در فاصله 0.9 تا 1.2 واحد نجومی رهگیری کند، یعنی تقریبا در مسیر مداری زمین، و مهمتر اینکه مسیر آن باید صفحه دایرهالبروج را در نقطهای که زمین حضور دارد قطع کند.
فضاپیما همچنین باید زاویه خورشید را بین 45 تا 135 درجه حفظ کند تا پنلهای خورشیدی به درستی کار کنند. عبور از کنار دنبالهدار نباید سرعتی بیش از 70 کیلومتر بر ثانیه داشته باشد، زیرا برخورد با گرد و غبار میتواند پروبهای کوچک CI را که برای مطالعه هاله دنبالهدار آزاد میشوند، نابود کند. همچنین، دنبالهدار باید میزان گاز خروجی مناسبی داشته باشد: نه کم که جذابیت نداشته باشد و نه زیاد که پروبها را تخریب کند؛ دنبالهدار هالی بهعنوان حد بالای مناسب برای میزان گاز در نظر گرفته شده است.
برای مطالعه بیشتر: واکنش ایلان ماسک به گمانهزنیهای جنجالی درباره دنبالهدار 3I/ATLAS + ویدیو
02
از 02محدودیتهای ماموریت Comet Interceptor
نویسندگان تحلیل خود را روی دنبالهدارهای تاریخی از دو منظر انجام دادند. ابتدا به نمونههای علمیترین و جذابترین دنبالهدارها توجه کردند. محدودیتهای این روش شامل بررسی فقط دنبالهدارهایی بود که وارد منظومه شمسی میشوند پس از اعمال این فیلتر، ۹ کاندیدای بالقوه باقی ماندند، اما بررسی دقیق نشان داد که هیچیک با محدودیتهای مهندسی ماموریت قابل دسترسی نیستند؛ بیشتر آنها یا خیلی دور از مسیر زمین بودند یا رسیدن به آنها نیازمند طی کردن مسافت بسیار طولانی بود.
در عمل، دنبالهدارهایی انتخاب شدند که با بودجه دلتا-وی ۱.۵ کیلومتر بر ثانیه قابل دسترسی باشند و در عین حال فعالیت کافی داشته باشند. این فیلتر سه دنبالهدار باقی گذاشت، همگی در ۲۵ سال اخیر کشف شده بودند. جالبترین آنها C/2001 Q4 (NEAT) بود که در سال ۲۰۰۱، حدود ۲.۵ سال قبل از رسیدن به حضیض، کشف شد. این دنبالهدار سطح فعالیت مناسبی داشت و با دلتا-وی ماموریت قابل دسترسی بود، اما سرعت عبور بالا (۵۷ کیلومتر بر ثانیه) محدودیت ایجاد میکرد و زمان حضور کافی برای جمعآوری دادههای ارزشمند فراهم نمیکرد.
به طور واقعبینانه، احتمال یافتن کاندیدای ایدهآل در بازه ۲-۳ ساله ماموریت CI اندک است. از این رو، ماموریت احتمالا باید یک هدف «قابل قبول» انتخاب کند و دادههای ممکن را جمعآوری نماید. این محدودیت ذاتی ماموریتهایی است که هدف نهایی قبل از طراحی و پرتاب مشخص نیست. با این حال، با کمی شانس، CI میتواند هدف مناسبی پیدا کند.در خوشبینانهترین حالت، ماموریت حتی میتواند با یک دنبالهدار ناشناخته ملاقات کند.